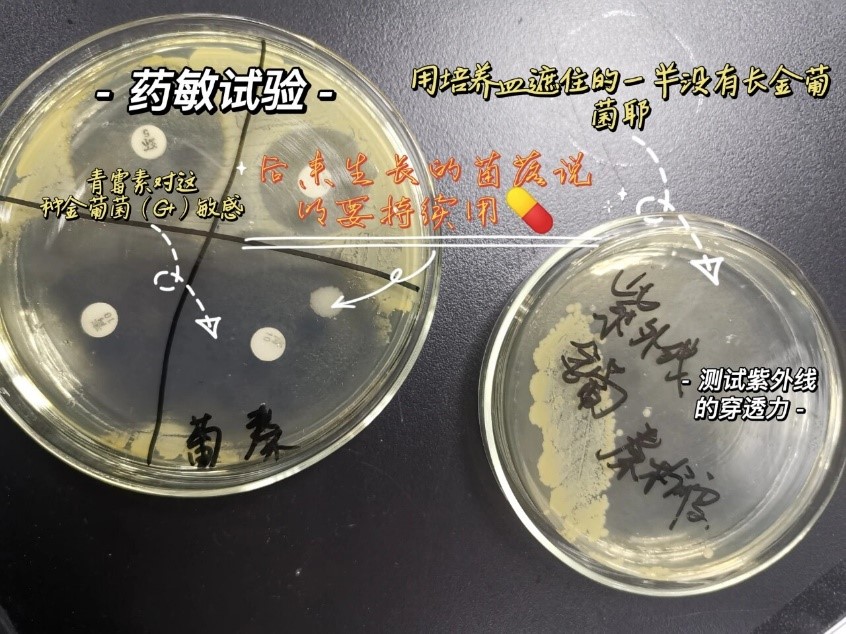

微生物藥敏試驗是指導(dǎo)臨床抗生素精準使用的關(guān)鍵環(huán)節(jié),但傳統(tǒng)手工操作存在耗時、誤差大及標準化程度低等問題。隨著耐藥菌的快速傳播,開發(fā)高效、準確的自動化藥敏檢測系統(tǒng)成為研究熱點。博清生物科技(南京)有限公司研發(fā)的自動分液系統(tǒng)作為新一代實驗室設(shè)備,結(jié)合高精度分液技術(shù)與智能化流程管理,有望解決傳統(tǒng)方法的局限性。
一、材料與方法
(一)實驗設(shè)備與試劑
1、自動分液系統(tǒng):支持96孔板分液,分液體積范圍1-2000μL,精度≤1.5%,具備振蕩混勻、回吸防污染功能。
2、藥敏試劑:采用CLSI推薦的肉湯微量稀釋法標準試劑,涵蓋常見抗生素(如青霉素、頭孢菌素等)。
3、質(zhì)控菌株:大腸埃希菌ATCC 25922、金黃色葡萄球菌ATCC 29213。
(二)實驗設(shè)計
1、傳統(tǒng)手工法:依據(jù)CLSI M07-A11標準,人工完成試劑分裝、接種及孵育。
2、博清系統(tǒng)法:通過預(yù)設(shè)程序自動完成分液、加樣及質(zhì)控流程,孵育條件為35℃、18-24小時。
(三)評價指標
1、分液精度:通過稱量法檢測10μL、50μL、100μL分液體積的CV值。
2、操作時間:對比兩種方法完成96孔板藥敏試驗的總耗時。
3、結(jié)果一致性:采用微量肉湯稀釋法(金標準)驗證博清系統(tǒng)的MIC值準確性。
二、結(jié)果與分析
(一)分液精度驗證
博清系統(tǒng)在10μL、50μL、100μL分液體積下的CV值分別為1.8%、1.2%、0.9%,顯著優(yōu)于手工操作(CV值分別為5.6%、3.8%、2.5%)。這一結(jié)果表明其高精度分液能力可有效降低實驗誤差。
(二)操作效率提升
博清系統(tǒng)完成單次96孔板藥敏試驗的總時間為25分鐘,較手工法(42分鐘)縮短 40.5%。自動化流程減少了人工干預(yù),尤其在批量處理時優(yōu)勢顯著。
(三)藥敏結(jié)果一致性
與金標準對比,博清系統(tǒng)對大腸埃希菌和金黃色葡萄球菌的MIC值符合率分別為98.3% 和96.7%,無顯著差異(P>0.05)。結(jié)果表明其性能滿足臨床檢測要求。
(四)抗污染設(shè)計效果
系統(tǒng)的8通道可拆卸分液模塊及紫外消毒功能有效避免了交叉污染,連續(xù)運行100次后未檢測到殘留(檢測限<0.1μL)。
三、討論
(一)技術(shù)優(yōu)勢
博清系統(tǒng)的氣壓式液面探測和動態(tài)液位補償算法確保了不同板型和液體粘度下的分液穩(wěn)定性。其模塊化設(shè)計支持多場景擴展,如真菌藥敏試驗(需調(diào)整接種濃度至2-5×10? CFU/mL)。
(二)臨床應(yīng)用價值
系統(tǒng)與LIS系統(tǒng)的無縫對接實現(xiàn)了數(shù)據(jù)自動上傳和報告生成,符合CLSI M27-A4和 EUCAST E.DEF 7.3.2標準。在急診場景中,其快速檢測能力(如尿液樣本3小時出結(jié)果)可顯著縮短患者等待時間。
(三)局限性與展望
當(dāng)前系統(tǒng)對高粘度試劑(如含血清培養(yǎng)基)的分液速度較慢(約15秒/板),未來可通過優(yōu)化泵體設(shè)計進一步提升效率。此外,針對罕見耐藥菌的個性化藥敏方案仍需人工干預(yù)。
博清生物科技(南京)有限公司研發(fā)的自動分液系統(tǒng)通過自動化流程和高精度技術(shù),顯著提升了微生物藥敏試驗的效率和準確性。其性能符合國際標準,為臨床實驗室提供了可靠的解決方案。未來結(jié)合人工智能算法,有望實現(xiàn)更智能化的藥敏結(jié)果預(yù)測。





